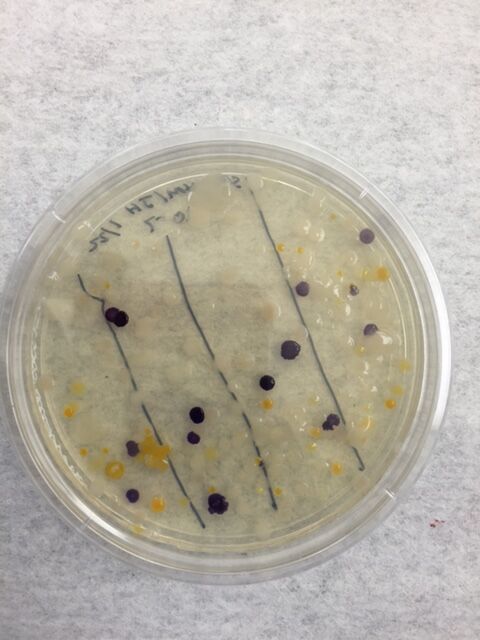
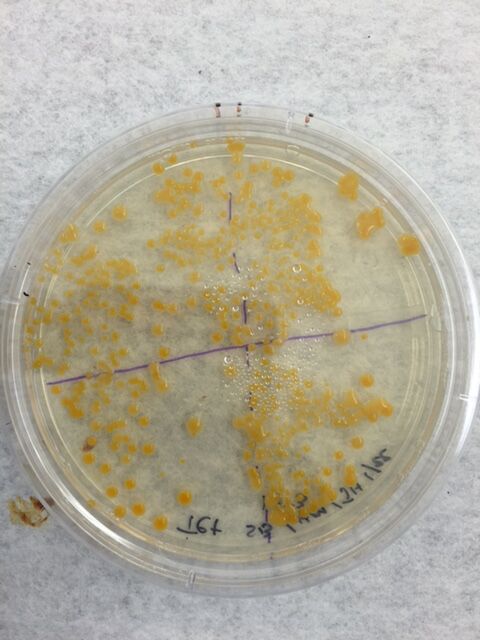
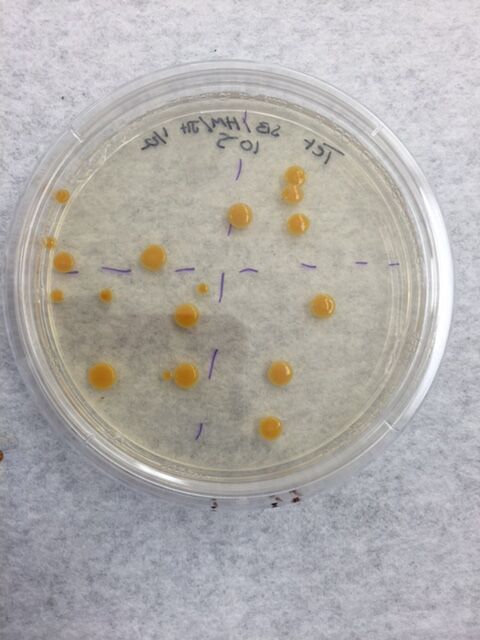

User:Sirah P. Bah/Notebook/Biology 210 at AU
Vertebrate Analysis and Food Web 03/10/16
Identification of Vertebrates found in transect 1: There were no vertebrates found in this transect probably due to the fact that it was studied in the dead of winter, and the vertebrates that did inhabit the transect migrated to a more practical habitat to survive. However, there were a couple of invertebrates found in the transect. Invertebrates found include Fleas Siphonaptera, and annelids. However, from obeservatation of similar prairies in warmer conditions, vertebrates capable of living or passing through include birds, deer, rats, etc.
Food Web Construction The food web constructed from most susceptible to prey to least susceptible to prey goes as follows... Annelid --> Fleas Siphonaptera
food web for vertebrates-> rats (at the bottom) --> birds ---> deer
Sirah P Bah ------
PCR Sequencing 03/3/2016 Sequence 1 (MB14) NNNNNNNNNNNNNNNGNNANNNCNTGCNNNNNNANAGGAACGNANTCTTANGNTTCTCGGCAGAGGGGTGAGGGTGCGGTNAANNNGNGGAAACTGACGTGAGCNGGGGGAAGNNCTTNCCACCGGTANAGTANAACCCCCANATAAAAATCNAGGCAACTCTCANTATGAACTGGTCCGGTGGATACAGNAGCNCTCGCCCCAGATGATACANTNGGTAGGGTAACGGCCCCCCACGTCTGTGATCTTTGTGGGGNCTGANANGNNGATCCCCCACACTGGTACGGANACACGGACCCNACACCTATGGGAGGNGGCTCAGATGAGCATTGGACNGTGGGTGANNGNNNGATNTGTACANCCNGTCTGNNATTGTANAGCNNTTTGGGTTGGANCNTATTTTGNNGCGGGAACATTGNTCGCNNATGTTTCACGCTGAAGNTTNANTTTAAACTCTNTACGNNGNNGCCNNTTATACCAACCGTGCACNCATTAATCGNANTTACTGANCNTANAGAATTNNANGTTTTTTGTTANTTGAACNTGAAACCNCGGGCTCAACCTGGNACTGCATCCNAAACTGGCCAGCTAGANAAGGTCNANGGTGGTNCAATTTGCTGTGTACCTGTGAATGGNTAATATNTCACGGAACAAGAGTGCCGAATGCNACCNCCGNACGATACTGACACTGANTNCAGCCGCNTGCGAACAAACANNNTTAGATACCGTGGTNNTCTACGCCTNNGACNANGTCNACTANCANNGGNATCCTTNAGNTNNACTGNCGACCTCANCCNTTAATTTGACCNNGGNNNAGTGCNNNNNCANNNNAANNTCNNAGNNATTTNAAGCCGCCCGCACGNGAGGAGGAGCNNGTNGTTNNNNTNNAANNGCNANAAAAGCTTNGCNNNNCCNNNCNGNGAGNNNANTTTNTTNNNNGNNATNAGTACNNTCNNNNA
Results: The first DNA sequence was unable to report back the identification of it. I think the reason in which the reading was inconclusive was due to the fact that this sample had no priming.
Sequence 2 (MB15) NNNNNNNNNNNNNNNNNNNNNAAACNNNNNNNTNNNNNNNGGATCGNGGTNTAGTNNNGNNCTGNNNTGAGGAGTANGGG AGNNNNNNNNNNNNNAGGNAAACTGCCNGATGGAAGGGGATAACTACNNGNANGGGNANCTAATACCGCACAACGTCNCA NGACCAAGGAGGGGGACCTTCGGGCCTCTTGCCATCANATGTGCCCAGATGGGATTAGCTNGGAGGTGGGGTAATGGCTC ACCTAGGCGACGATCCCTANCTGGTCTGANAGGATGACCAGCCACACTGGAACTGAGACACGGTCCACACTCCTACGGGA GGCAGCANTGGGGAATATTGGGAATGGGCGCAGACCTGATGCGCCATGCCGCGTGTATNANNAACGCCTTCGGGTTNTAA AGTACTTTCAACGAGGAGGAAGGCATTGAGGTTAATAACCCCNGTGATTGACGTTACTCNCAAAAAAAGCACCAGCTAAT TCCNTGCCANGCGCCACTANTAATACGTGGNGGCGNNGCNTTAATTTACANTTACNGNGCNTAGAGCACGCGCNNGCGNN CTTTCAANTCGGAANTNAAGTCCTCCNGCTCAGCCTGGGAACTGCNTTCNAGACTGNNANGCTGNAATCTTGTANAGAGA ATGTANAATTCCNNATNTAACGGGTGAAATGCNNNGANAGATGAGGGGAATGCCCGTGGGGGCGNGTCGNNCCGNGGTGG ANAGAGAGTGAGNCTAANGTGCGGGAAGGNTGGAGAGGATGAGAAGGATGCGATAGTCCNNNNNGTCGACNNGNNANACN ATCTCAANNTNNNNTTNNNGCTCGNNNNNNGTNNCTGTCCGCANNNNAGGAGTTGACNNNGCCGCGCGGTNGAAGAGTAN NNGANNGTGAAANGCACNGGGAGNTNACNCGAGCCGCCGNANNANGNGNTNTAACTTGTANGTTNNTTAGNAGNGCGNGN GNTGNNCATNNGCGCNNGACAGGATTCCCGCNGNGGNGAG
Results: Genus --> bacteria After consulting the microbiology lab post looking at the results from the NCBI Blast, the colony morphology, gram stain and bacterial cell shape could not be established as correct or incorrect. The sequence that was registered was unable to be completely sequenced, as the the blast generator said it was "partially sequenced". In the physical lab portion the sample sequenced was analyzed to be organized in singletons on the slide and was not organized in clusters. The bacteria analyzed was long (almost resembling a string), not motile, oblong, and gram negative. OWW Notes:
- There was a difference in the colony between the plates with versus without antibiotic. The plates with agar created larger dots and were more spread out. This indicates that the tetracycline leads to bacteria clusters that are held more tightly together and smaller size of the bacteria
- The effect of tetracycline on the total number of bacteria was the lower the dilution would result in a greater number of surviving colonies. Tetracycline is an antibiotic, so it's purpose is to kill bacterias.
Sirah Bah -----
Invertebrates 02/25/2016 For this lab there was a need to set up a Bernese Funnel to gather further information regarding what could have possibly grown from the transect undergoing the numerous tests. The primary step was in adding 25mL of 50:50 ethanol/water mixture to a 50mL conical tube. After the solution was added to the tube, a mesh screen was placed in the funnel and attached using pieces of tape. Once the screen was set in place a leaf sample from the transect was added to the funnel. The funnel was then attached to a ring stand , and paraflim was added around the base of the funnel in order to attach it to the tube. This concluded the official set up of the funnel, so to finish it a 40 watt lamp was placed 1-2 inches above it, and covered in foil.
Invertebrate Description Table
 Conclusion: The size range of the samples were not able to be accurately concluded due to errors involving the microscope. The organism identified in the leaf litter that was the most common was the Annelid sample. It can also be concluded that the organisms identified from the leaf litter under the microscope, and that there was great diversity within the organisms.
Conclusion: The size range of the samples were not able to be accurately concluded due to errors involving the microscope. The organism identified in the leaf litter that was the most common was the Annelid sample. It can also be concluded that the organisms identified from the leaf litter under the microscope, and that there was great diversity within the organisms.
Photos of Organisms Identified
 http://www.microbehunter.com/the-dog-flea-ctenocephalides-canis/
http://www.microbehunter.com/the-dog-flea-ctenocephalides-canis/
 http://www.microscopy-uk.org.uk/index.html?http://www.microscopy-uk.org.uk/pond/worm/oligo.html
http://www.microscopy-uk.org.uk/index.html?http://www.microscopy-uk.org.uk/pond/worm/oligo.html
Sirah Bah -----
Plantae and Fungi 02/15/16
In transect one there were five samples of life that could be identified. One sample was a branch that was found near the foot of the large tree in the center of the transect. The branch was long and skinny, and we concluded that it did not perform vascularization. The specialized structures associated with the branch include needles as leaves, and it participated in monocotic reproduction. The second sample identified was a long fern, found near the sprinkler in the lower left quadrant of the transect. There was a long network of tubes present for its vascularization. We were unable to determine any specialized structures,howeve, we concluded that it was a monocot. he third sample found was a small fern near the back of the transect in the upper right quadrant. The fern was very small and looked like a short leaf. We determined that it was vascular, that there were not any specialized structures, and that it is a monocot. The fourth sample was a small clover found in the middle left of the quadrant near the large tree in a small cluster of other clovers. The clovers are vascular, dicot reproduction, and its specialized structure is its veiny composition. The last sample gathered from the transect was a dead leaf. This lead was found at the foot of the tree, and was about regular leaf size. Again, the leaf was vascular, and its specialized structure was a stem connection throughout the entire structure. We determined that the lead was a monocot.
Fungi sporangia are structures formed by hyphae that grow small black circular structures. They are important, because they release chemicals and other things from their structure in the air with the spores develop which help provide nutrients for various organisms. I chose a lichen to analyze, and it is a fungus (zygomycota).

--- Sirah Bah ---
Microbiology and Identifying Bacteria 02/11/16
Observations of Hay Infusion Culture: Water levels decreased significantly in the culture, and retained a dark brownish/black color. When the lid was opened an odor of rotten eggs. The leaves that were left in the culture were very dark, and looked as though they were beginning to mold. The soil has still settled to the bottom of the container. At the top of the culture there looked to be a semi-permeable layer of much. Dirt was also clamped to the walls of the container.
Serial Dilution Results Table:
Yes there are differences in the colony types between the plates with versus without antibiotic. The plates with agar created much larger dots and there were more spread out. The effect of tetracycline was that these plates displayed dots grouped closer together. This makes sense, because lower dilution= increase colonies, and since tetracycline is an antibiotic, it was trying to kill bacterias.
Mechanisms of Action for tetracycline... Tetracylines performs as a protein synthesis inhibitor, and because of this function it works to kill the 30S ribosome. Can work against aerobic gram positive and gram negative species
Source: Kohanski, M., Dwyer, D., Collins, J. 2010. How Antibiotics Kill Bacteria. Nature
Reviews. 8: 423-425
Bacteria sensitive to tetracycline... Chlamydia, Mycoplasma and Rickettsia http://mmbr.asm.org/content/65/2/232.full
Bacteria Characterization Table:

Materials and Methods for gram stain, DNA isolation, and PCR amplification: First a loop needs to be held over a flame in order to sterilize it, and scare off the bacteria sample to mount. After this to prepare the slide add one drop of water. With a red wax pencil circle where the bacteria was placed. Heat fix the slide, and then rinse with crystal violet for a minute. After the rinse, rinse it with water and perform the same process three more times with gram's iodine mordant, 95% alcohol, and safranin stain while alternating between rinses with water. When the rinses are complete dab the slide dry with a kimwipe, and look at the stain slide under a microscope. For PCR amplification isolate two plates from which the sample will be obtained. Put samples into two separate microbes, and add 20 micrometers of primer. Flick tube around for about 5 seconds, and place the tubes into the PCR machine.
Pictures of colony morphology, gram stains, and motility studies...

--- Sirah Bah ---
"Algae and Protist" 02/4/16
After a week of the Hay Infusion sitting in the lab descriptions of it were able to be made. The dirt and leave fragments settled to the bottom of the container. When the lid was removed from the container an odorous stench of something rotten and putrid emanated. The watery mixture that inhabited the bottle was a dark brown, and cloudy color. The water also displayed a tint of green. At the top there was signs of apparent life, and it looked similar to a brownish mold.
Samples of two Niches:
 The organisms differ close to versus away from the plant matte, because of ecological diversity.
The organisms differ close to versus away from the plant matte, because of ecological diversity.
The protists and the algae present include the gloeocapsa which are motile algae that use photosynthesis for their nutrients. They are 5 micrometers at 40x, and are green. The gloeocapsa were found at the top of the hay infusion. In the middle of the hay infusion Arcella was found. Arcella are circular, white motile algae. The arcella uses photosynthesis as well, and was size 1 line at 10x or 10 micrometers. At the bottom section of the hay infusion were amoeba. Amoeba are large, dark green motile circular protists. They were measured to be 5 micrometers at 10x.
The gloeocapsa meets all the needs of life as it can reproduce, made up of cells, capable growth and development, maintains homeostasis, and uses energy. If the hay infusion “grew” for another couple of months, a range of changes would occur. I would expect to see great bacteria growth, and the development of new organisms. Some selective pressures that would affect the community of the samples are temperature, humidity, motion (disturbing the habitat), sunlight, and human interference.
-- SPB--
Transect photos and descriptions: 01/28/16
List of biotic components: Trees, Shrubs,
List of abiotic components: Sprinkler system, trash (receipts, cigarette butts), Light post
General description: The transect is located on the north eastern end of campus. It is skirted by a sidewalk on 2 of its ends, and borders Ward Building. There is a large patch of dirt that takes up a majority of the transect space. There are several small trees, bushes, and sprinkler systems scattered across the space. There is a large, tall tree in the center of the transect.



 --- SPB ---
--- SPB ---



